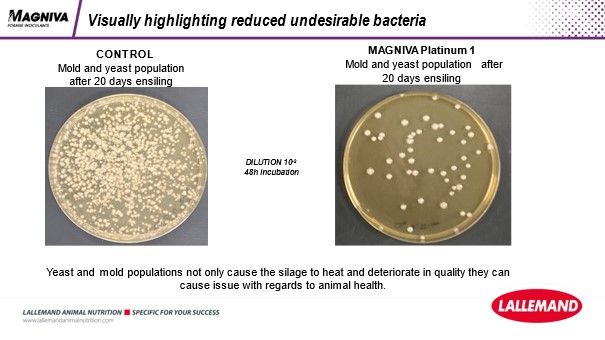

Magniva Platinum 1 on bioloogiline silokindlustuslisand maisisilole, mis on spetsiaalselt välja töötatud sellise värske sööda aeroobse stabiilsuse parandamiseks, milles on suur vees lahustuvate süsivesikute ja kuivaine sisaldus.

Maisil on kõrge suhkrute sisaldus ja tänu sellele fermenteerub maisisilo kergesti ja kiiresti. Hiljem on kõige suurem oht maisisilo puhul kuumenemine, mida põhjustavad kiirelt paljunevad hallitus- ja pärmseened.
Platinum 1 tagab maisisilo aeroobse stabiilsuse avamisjärgselt, hoides ära kuumenemise pärast siloaugu avamist.
Magniva Platinum 1 eelised:
Magniva Platinum 1 tagab maisisilo aeroobse stabiilsuse avamisjärgselt, hoides ära kuumenemise pärast siloaugu avamist.
Toode sisaldab kahte heterofermentatiivset bakterit: L. Hilgardii CNCM I-4785 ja L. Buchneri NCIMB 40788. L. Hilgardii on uus Lallemandi poolt patendeeritud heterofermentatiivne bakter. L. Hilgardii ja L. Buchneri piimhappebakterite omavaheline sünergiline koosmõju annab tulemuseks kiire sileerumise ning väga hea avamisjärgse stabiilsuse.
Tänu Magniva Platinum 1 kasutamisele on võimalik aeroobne stabiilsus silos saavutada lühikese fermenteerimisajaga, 15 päevaga. Vajadusel saab silo kasutusele võtta juba kaks nädalat pärast valmistamist.
NB! Soovitame siiski maisisilol rahulikult sileeruda vähemalt 60 päeva, võimalusel isegi 90 päeva. Sellisel juhul on kõik protsessid jõudnud toimetamised ära toimetada, silo on stabiilne ja kõige täisväärtuslikum loomadele.
Magniva Platinum 1'ga valmistatud silol on väiksem äädikhappe ja etanooli sisaldus. See tagab maisisilo parema söömuse, sest silol säilib looma jaoks meeldiv lõhn ja maitse.
Mis põhjustab silo kuumenemist?
L. Buchneri ja L. Hilgardii piimhappebakterid ei lase pärmseentel tekkida.
Magniva Platinum 1 on veega segunev valkjashall pulber.
Kõik Lallemandi silokindlustuslisandid on HC tehnoloogiaga ühtlase lahuse püsimiseks.
HC ehk High Concentration (ingl k kõrge kontsentratsioon) on Lallemandi välja töötatud tehnoloogia tagamaks, et bioloogilise silokindlustuslisandi lahus püsiks kasutamisel stabiilne ja homogeenne.
HC tehnoloogia on end tõestanud ning seda rakendatakse juba kõigis Lallemandi Lalsili silokindlustuslisandites. HC abil välditakse settimist paagis enne kasutamist ja kasutamise ajal ning tagatakse ühtlasem jaotumine silomaterjalis. Kõrge kontsentratsiooniga lahus võimaldab silo tegemisel mugavalt kasutada väikest paaki ja lisamismäära.
HC lahus püsib homogeensena 24 tundi alates valmistamisest ning ei ummista lisandi dosaatorit. Peale ööpäevast seismist on enam kui 80% bakteritest elus ja aktiivsed, seega saab lahust hoiustada ka järgmiseks päevaks.
Platinum 1 sisaldab kahte heterofermentatiivset bakterit: L. hilgardii CNCM I-4785 ja L. buchneri NCIMB 40788. L. hilgardii on uus Lallemandi poolt patenteeritud heterofermentatiivne bakter. L. hilgardii ja L. buchneri piimhappebakterite omavaheline sünergiline koosmõju annab tulemuseks kiire sileerumise ning väga hea avamisjärgse stabiilsuse.
Heterofermentatiivsed bakterid toodavad lisaks piimhappele ka äädikhapet ja propioonhapet.
Sellised bakteritd töötavad hallituste ja pärmide vastu, mis sisuliselt tähendab, et silo ei lähe õhuga kokku puutudes kuumaks ning ei hakka uuesti käärima. Väga suhkrurikkad silomassid, näiteks varane kõrreliste niide ja maisisilo, vajavad kindlasti heaks käärimiseks heterofermentatiivsete bakterite tuge. Näiteks Lactobacillus buchneri, Lactobacillus brevis, Lactobacillus Hilgardii jm.

Magniva Platinum silokindlustuslisandeid toodab Lallemand, mis on Euroopa üks juhtivaid silokindlustuslisandite tootjaid ja uurijaid. Kõik kasutatavad bakterid on Lallemandi laborites leitud ja kontrollitud ning katsetatud ka sõltumatutes laborites. Bakterite L. Hilgardii CNCM I-4785 ja L. Buchneri NCIMB 40788 koos kasutamine on patenteeritud ning ainulaadne kombinatsioon Euroopa turul.
Bakterite hulk
| L. hilgardii CNCM I-4785 |
150 000 CFU/g 1.5 x 1011 CFU/g tootes |
| L. buchneri NCIMB 40788 |
150 000 CFU/g 1.5 x 1011 CFU/g tootes |
Kasutamine
200 g pakikesest piisab 200 tonni värske maisimassi sileerimiseks.
| Pakend | 200 g |
| Tootja | Lallemand |
Ungaris Szegedi ülikoolis läbi viidud katses mõõdeti maisisilo aeroobset stabiilsust pärast 100 päevast ja 250 päevast fermenteerumist. Katse tõestas, et Magniva Platinum 1 kasutamine kontrollib maisisilo stabiilsust väga edukalt, pikendades aeroobse stabiilsuse perioodi isegi kuni 263 tunni (15 päeva) võrra.
| Aeroobne stabiilsus, h | Erinevus kontrollist, h | |||
| Sileerimisaeg | 100 päeva | 250 päeva | 100 päeva | 250 päeva |
| Kontroll | 97 | 102 | 0 | 0 |
| L. buchneri | 123 | 138 | 26 | 36 |
| L. hilgardii | 119 | 124 | 22 | 22 |
| Magniva | 147 | 365 | 50 | 263 |


